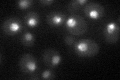
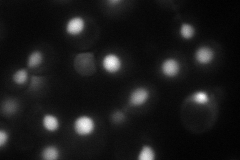
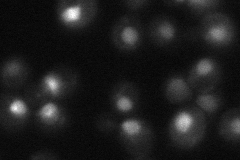
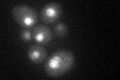

View description
Protein required for establishment and maintenance of sister chromatid condensation and cohesion, colocalizes with cohesin on chromosomes, may function as a protein-protein interaction scaffold; also required during meiosis
Localization:
Intensity:
Fold change:
Significance:
-
C’ GFP library in SD
nucleus33.24 -
N' NOP1pr-GFP in SD
nucleus81.6068 -
N' TEF2pr-mCherry in SD

nucleus82.6743 -
N' NATIVEpr-GFP in SD
nucleus39.1591 -
N' TEF2pr-VC and Cyto-VN in SD

#N/A0 -
C’ GFP library in SD+DTT
vacuoleN/AN/AYes -
C’ GFP library in SD+H2O2

nucleus33.241No -
C’ GFP library in Starvation Media

nucleus19.710.59Yes -
C’ GFP library on the background of Pup2-DaMP

N/A -
C’ GFP library on the background of CCT mutant

N/A0N/AYes
